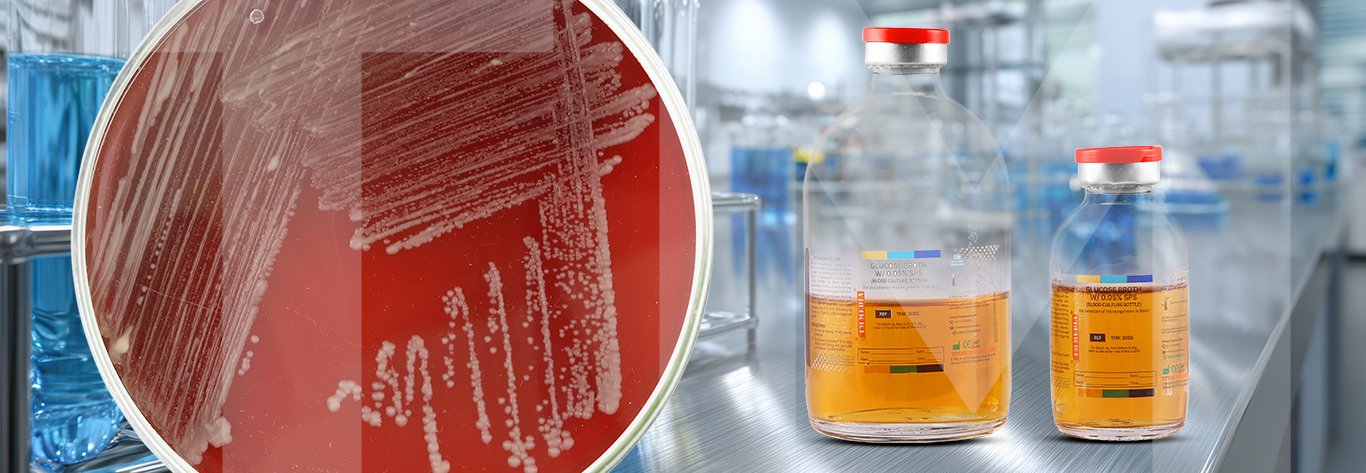
Clinical Diagnostics

10,000+ Products Internationally Certified
Learn more
Trusted by 15000+ Microbiologists in 100+ Countries
Learn more
Fulfilling Microbiology Needs
Learn more
10,000+ Products Internationally Certified
Learn more